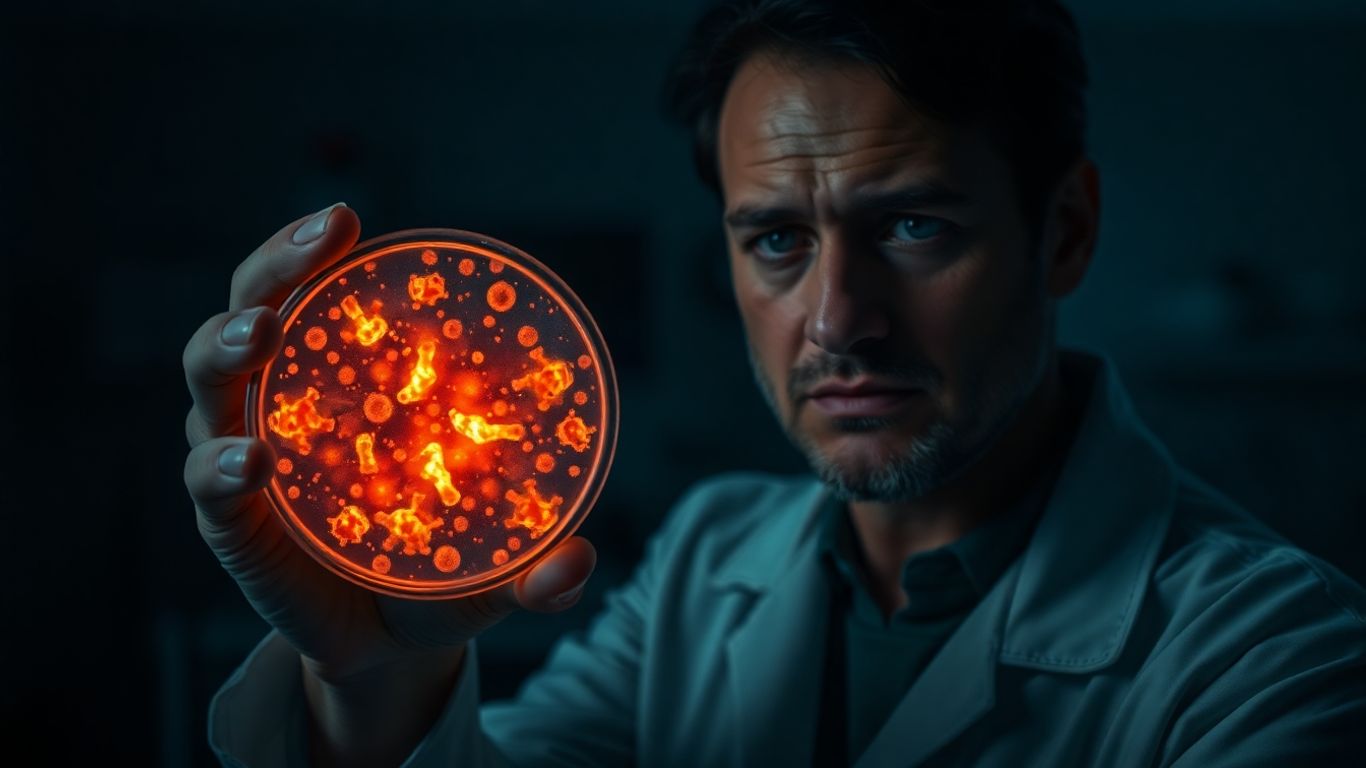

L’Organisation Mondiale de la Santé (OMS) vient de lancer une alerte sérieuse : la résistance aux antibiotiques, ce fléau qui rend les infections bactériennes de plus en plus difficiles à soigner, pourrait causer une augmentation massive des décès d’ici 2050. On parle d’une hausse de 70%, ce qui est juste énorme et franchement effrayant. En gros, nos médicaments actuels deviennent moins efficaces face aux bactéries qui mutent et s’adaptent. C’est un peu comme si les bactéries devenaient plus intelligentes que nous, et ça, ça pose un sacré problème pour la santé mondiale.
Points Clés à Retenir
- La résistance aux antibiotiques progresse rapidement, avec une augmentation de plus de 40% observée entre 2018 et 2023 pour certains médicaments.
- Si rien ne change, l’OMS estime que 70% de décès en plus pourraient survenir d’ici 2050 à cause des infections bactériennes résistantes.
- Une infection bactérienne sur six est déjà résistante aux antibiotiques dans le monde, un chiffre qui inquiète les experts.
- Les régions avec des systèmes de santé plus faibles, comme l’Asie du Sud-Est et la Méditerranée Orientale, enregistrent les taux de résistance les plus élevés.
- Il y a un manque alarmant de nouveaux antibiotiques et de tests de diagnostic en développement, rendant la lutte contre ce phénomène encore plus compliquée.
L’OMS Tire la Sonnette d’Alarme sur une Crise Sanitaire Mondiale
L’Organisation Mondiale de la Santé vient de publier un rapport qui donne froid dans le dos. Nos antibiotiques, ces médicaments qui nous ont tant sauvés, perdent de leur efficacité face aux bactéries. C’est un peu comme si les clés commençaient à ne plus ouvrir les serrures. Les chiffres sont là pour le prouver : une infection bactérienne sur six, déjà, résiste aux traitements habituels. C’est une augmentation qui fait réfléchir, surtout quand on sait que ce phénomène s’est accentué ces dernières années. On parle d’une véritable crise sanitaire qui se profile si rien ne change.
La Résistance aux Antibiotiques Augmente de Manière Alarmante
Ce n’est plus une petite augmentation, c’est une vraie montée en puissance. Les bactéries mutent, elles s’adaptent, et nos vieux remèdes ne font plus autant d’effet. On voit ça partout dans le monde, et ça devient un vrai casse-tête pour les médecins. Le problème, c’est que cette résistance ne s’arrête pas ; elle continue de progresser, rendant les infections courantes de plus en plus difficiles à soigner.
Une Menace Croissante pour la Santé Publique Globale
Imaginez un monde où une simple coupure pourrait devenir mortelle parce que les antibiotiques ne fonctionnent plus. C’est un peu le scénario catastrophe que l’OMS agite devant nous. Cette résistance aux antibiotiques, c’est une menace qui pèse sur nous tous, peu importe où l’on vit. Elle complique le traitement des infections, rend les opérations chirurgicales plus risquées et met en péril les progrès médicaux qu’on a faits.
Des Antibiotiques De Moins en Moins Efficaces Contre les Bactéries
C’est le cœur du problème. Les bactéries deviennent plus fortes, plus intelligentes, et nos antibiotiques, eux, ne suivent plus le rythme. On a utilisé ces médicaments pendant des décennies, parfois sans vraiment faire attention, et les bactéries ont eu le temps de développer des stratégies pour leur échapper. Résultat : les traitements qui fonctionnaient avant ne suffisent plus aujourd’hui pour venir à bout de certaines infections.
Une Hausse Dévastatrice des Décès Attendue d’ici 2050
Imaginez un monde où une simple coupure pourrait devenir mortelle. C’est la direction que nous prenons si rien ne change. L’Organisation Mondiale de la Santé (OMS) tire la sonnette d’alarme : d’ici 2050, on estime que les infections causées par des bactéries résistantes aux antibiotiques pourraient entraîner 70% de décès en plus. C’est un chiffre qui donne froid dans le dos, n’est-ce pas ? On parle ici de millions de vies perdues chaque année, un véritable fléau sanitaire mondial. Les superbactéries, ces microbes devenus invincibles face à nos médicaments habituels, sont au cœur du problème. Elles se développent et se propagent à cause de notre utilisation massive et souvent inappropriée des antibiotiques, que ce soit en médecine humaine ou dans l’élevage. C’est une course contre la montre, et pour l’instant, la résistance semble prendre le dessus.
Des Données Mondiales Révèlent une Propagation Inquiétante
Les chiffres que l’Organisation Mondiale de la Santé (OMS) vient de publier donnent vraiment à réfléchir. Ils ont analysé des données provenant de plus de 100 pays, et ce qu’ils ont trouvé est assez alarmant. En 2023, on estime qu’une infection bactérienne sur six, confirmée en laboratoire, montrait déjà une résistance aux antibiotiques. C’est une augmentation significative par rapport aux années précédentes, et ça montre bien que le problème s’aggrave à un rythme soutenu.
Ce n’est plus une menace lointaine, c’est une réalité qui touche le monde entier. Les bactéries qui nous rendent malades deviennent de plus en plus difficiles à combattre, et cela concerne des infections courantes comme celles des voies urinaires ou des infections sanguines. Les données recueillies entre 2018 et 2023 indiquent une hausse de plus de 40% de la résistance pour certains antibiotiques surveillés, avec une augmentation annuelle moyenne qui peut aller jusqu’à 15%. C’est une tendance qui nous pousse vers un avenir où nos médicaments actuels pourraient devenir inefficaces, un peu comme si on retournait à une époque où une simple infection pouvait être mortelle. Cette situation nous rappelle l’importance de suivre les objectifs de développement durable, notamment ceux liés à la santé et au bien-être [7720]. Les systèmes de santé, partout dans le monde, doivent faire face à cette réalité grandissante.
Les Systèmes de Santé Fragiles Sont les Plus Touchés
C’est dans les régions où les systèmes de santé sont déjà sous tension que la résistance aux antibiotiques frappe le plus fort. On observe les taux les plus élevés en Asie du Sud-Est et dans la région de la Méditerranée orientale. Là-bas, une infection sur trois présente déjà une résistance aux traitements. Cela s’explique en partie par un manque de moyens pour bien diagnostiquer les infections et proposer des traitements adaptés. De plus, dans de nombreux pays, les données de surveillance sont incomplètes, ce qui nous fait avancer un peu à l’aveuglette. Il est difficile d’avoir une image claire de la situation quand on ne dispose pas d’informations fiables sur tous les patients, surtout quand seuls les cas les plus graves sont signalés. Les données de surveillance sont donc un enjeu majeur pour comprendre et combattre ce phénomène.
Un Manque Crucial de Nouveaux Traitements et Tests
L’Organisation Mondiale de la Santé tire la sonnette d’alarme : le développement de nouveaux antibiotiques et de tests de diagnostic efficaces prend un retard inquiétant. On se retrouve avec une situation où les bactéries deviennent de plus en plus résistantes, mais où les outils pour les combattre n’évoluent pas assez vite. C’est un peu comme si on se battait contre un ennemi qui s’adapte constamment, sans avoir de nouvelles armes à disposition. Ce manque d’innovation est particulièrement préoccupant. On voit bien que l’utilisation des antibiotiques continue d’augmenter, et que les bactéries s’y habituent. Sans de nouveaux traitements et des tests capables de détecter rapidement les infections et leur résistance, on risque de se retrouver démunis face à des maladies autrefois faciles à soigner. La recherche avance, mais pas assez rapidement pour contrer la menace grandissante des superbactéries. Il faut vraiment accélérer les choses dans ce domaine, sinon les conséquences pour la santé publique mondiale pourraient être désastreuses.
Alors, que faire maintenant ?
Franchement, ça fait réfléchir. On voit bien que les antibiotiques, c’est pas juste pour quand on a un petit rhume. Ça devient sérieux, vraiment sérieux. L’OMS nous dit que d’ici 2050, on pourrait avoir 70% de morts en plus à cause de ça. C’est énorme. On a utilisé ces médicaments à tout va pendant des années, et maintenant, les bactéries se moquent un peu de nous. Il faut vraiment qu’on change nos habitudes, que ce soit nous, les médecins, ou même l’industrie. Sinon, on va droit dans le mur. On doit trouver de nouvelles solutions, et vite. Parce que là, on joue avec le feu.

Dima Khatib est une journaliste, écrivaine et traductrice syrienne d’origine palestinienne, née le 14 juillet 1971 à Damas (Syrie).
Elle est aujourd’hui l’une des figures majeures du journalisme numérique au sein du groupe Al Jazeera Media Network.
🎓 Formation
- Études en langues et traduction
- Université de Genève (formation universitaire en Suisse)
- Parcours académique international (Europe et Moyen-Orient)
🧭 Parcours professionnel
🏁 Débuts (années 1990)
Elle commence sa carrière dans les médias en travaillant :
- pour la Radio Suisse Internationale
- puis dans des institutions comme l’OMS à Genève
📺 Al Jazeera (depuis 1997)
Elle rejoint Al Jazeera en 1997 comme stagiaire journaliste.
Elle évolue ensuite rapidement vers des postes importants :
- productrice
- correspondante internationale
- cheffe de bureau en Amérique latine
- couverture de grands événements mondiaux (guerre d’Irak, révolutions arabes, Amérique latine)
🌎 Correspondante internationale
Elle a couvert plusieurs régions du monde :
- Chine
- Amérique latine
- Moyen-Orient
- Afrique et Europe
Elle a interviewé plusieurs dirigeants politiques en Amérique latine et couvert des événements majeurs comme les élections et crises régionales.
📱 Direction de AJ+
En 2015, elle devient Directrice exécutive de AJ+, la plateforme numérique d’Al Jazeera.
AJ+ est un média digital diffusé en :
- arabe
- anglais
- français
- espagnol
Son rôle :
- développement du journalisme digital
- stratégie réseaux sociaux
- formats vidéo courts pour audiences jeunes
- innovation éditoriale
🧠 Style et influence
Dima Khatib est reconnue pour :
- son rôle pionnier dans le journalisme digital
- son influence sur les réseaux sociaux dans le monde arabe
- son approche moderne du storytelling
- son engagement sur les droits humains et conflits internationaux
✍️ Autres activités
- Poétesse (recueil en arabe)
- Traductrice
- Conférencière internationale
- Enseignante ponctuelle en journalisme

Just a smiling visitant here to share the love (:, btw great design and style. « Individuals may form communities, but it is institutions alone that can create a nation. » by Benjamin Disraeli.